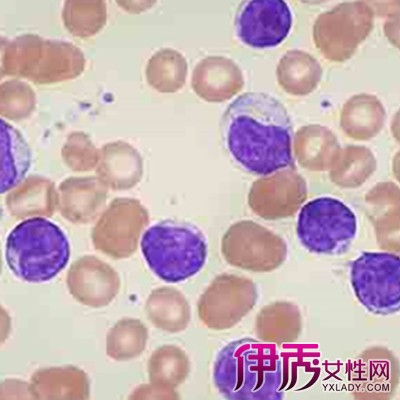

【图】慢性淋巴细胞白血病的病因 早发现早治疗
慢性淋巴细胞白血病是一种淋巴细胞克隆性增殖的肿瘤性疾病,淋巴细胞在骨髓、淋巴结、血液、脾脏、肝脏及其他器官聚集。95%%u4EE5上的CLL为B细胞的克隆性增殖
3.多毛细胞白血病 大多为B细胞来源,T细胞来源者极罕见,与CLL为两种不同疾病。临床上以脾中高度肿大伴血中出现典型的毛细胞,其含有酸性磷酸酶同工酶5,呈现耐酒石酸酸性磷酸酶染色阳性特点。具体鉴别见表1。
4.小淋巴细胞淋巴瘤 小淋巴细胞淋巴瘤与CLL在临床和生物学表现最接近。其预后及治疗亦相似。因而最新如Real和WHO临床分型标准均把二者划为一类。从淋巴结病理检查无法区分二者,但小淋巴细胞淋巴瘤开始不一定浸润骨髓,骨髓淋巴细胞比例<40%%uFF0C即使有骨髓浸润也以结节状浸润为主,而CLL多为弥漫型。
5.非霍奇金淋巴瘤白血病期 非霍奇金淋巴瘤转为淋巴瘤白血病时,其细胞胞体均大,核有折叠,细胞表面有高表达免疫球蛋白,CD5为阴性,以上这些特点均易与CLL相区分。
6.皮肤T细胞淋巴瘤 常伴有广泛皮肤浸润,其细胞核为脑回状。为来源于辅助T细胞(CD4)的非霍奇金淋巴瘤。
7.大颗粒淋巴细胞白血病(LGL) 通常淋巴细胞较CLL细胞大,有丰富的边界清楚的半透明胞质,内有大小不等的嗜天青颗粒,卵圆形或不规则胞核。其组织来源于NK/T细胞,来源于T抑制细胞(CD8)者免疫表型为CD3、CD4-、CD8、CDl6、CD56-、CD57 /-、有TCR基因重排;来源于NK细胞者,CD3-、CD4-、CD8-、CD16、CD56-、CD57/-。无克隆性基因异常。T细胞LGL临床病情呈惰性、慢性病程,常伴全血细胞减少和脾大。NK细胞LGL部分患者可呈急性爆发性起病,部分则呈慢性病程。
- 没有相关文章
- 上一篇文章: 【图】喝酒脸红怎么办 预防和治疗有门道
- 下一篇文章: 【图】半月板损伤能自愈吗 专家为你解答疑惑
粤ICP备18141124号-1 联系邮箱: webmaster@nvwu.com